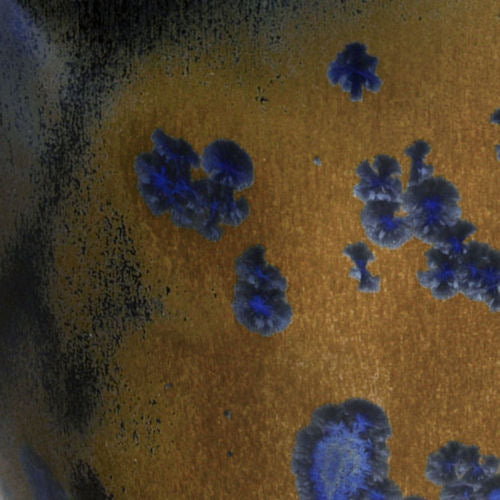

Coyote
Coyote Cone 6 Glaze Crystal Lagoon MBG162
Coyote Cone 6 Glaze Crystal Lagoon MBG162
Regular price
$16.29 USD
Regular price
$18.10 USD
Sale price
$16.29 USD
Unit price
per
Shipping calculated at checkout.
Couldn't load pickup availability
These new glazes look their best when cooled slowly. Most modern electric kilns are less insulated than their gas fired counterparts, resulting in a quick cooling cycle that prevents many glazes from developing the richness they might otherwise have. Iron reds, crystaline glazes and others should be slow cooled to achieve their best effects.
These new Cone 6 glazes from Coyote look fabulous in regular firings. A slow cool will maximize the growth of crystals and bring out the best in these glazes, but is not necessary to make them work well.
Materials
Materials
Shipping & Returns
Shipping & Returns
Dimensions
Dimensions
Care Instructions
Care Instructions